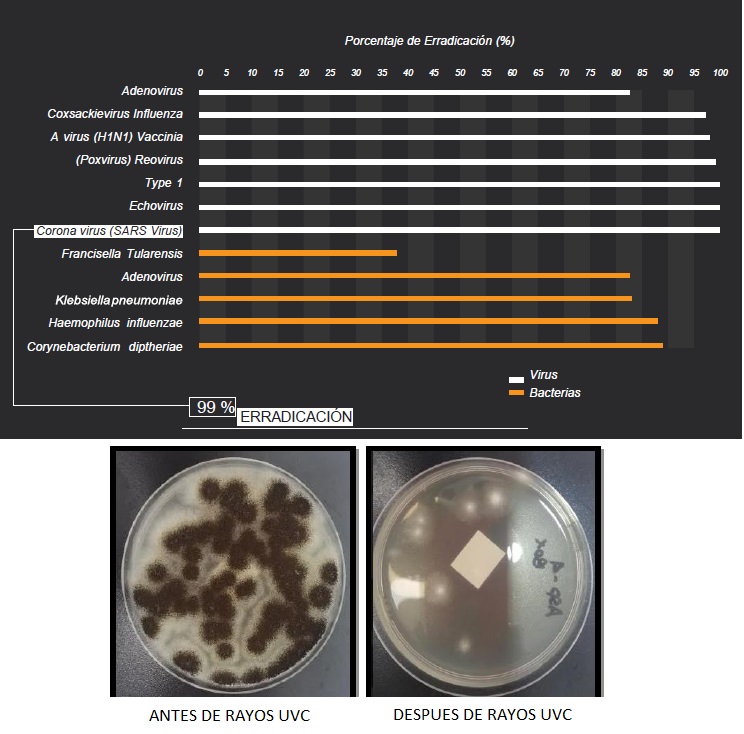

Ultravioleta Colombia
Realizamos procesos de desinfección, esterilización y automatización con luz ultravioleta en industrías de cosméticos, alimentos, clínicas, hospitales, servicios de transporte, restaurantes y hoteles.
PARA MAYOR INFORMACION HAGA CLICK EN EL SIGUIENTE BOTON O NO DUDESE EN CONTACTARNOS.
PARA MAYOR INFORMACIÓN HAGA CLIK AQUÍ